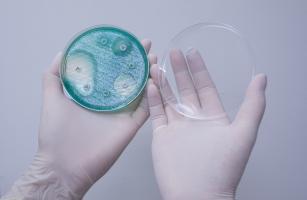
Lorsque les bactéries reçoivent le signal d’avertissement de leurs congénères, elles se déplacent en rond Lorsque les bactéries reçoivent le signal d’avertissement de leurs congénères, elles se déplacent en rond

C. DIFFICILE : La bactérie expose son armure

Cette équipe de virologues de l’Université de Newcastle, perce à jour l’armure protectrice de la superbactérie Clostridioides difficile ou C.difficile, une bactérie responsable d’infections nosocomiales entraînant des symptômes sévères, dont la diarrhée et des lésions massives dans l'intestin qui peuvent aboutir au décès : cette enveloppe protectrice, qualifiée de « spectaculaire » permet d’expliquer la capacité de la superbactérie à résister aux antibiotiques et aux composants moléculaires du système immunitaire. Ces travaux, présentés dans la revue Nature Communications, décrivent une sorte de cotte de mailles à la fois serrée et flexible, qui empêche les molécules d'entrer. C’est une nouvelle cible pour vaincre la bactérie qui vient ainsi d’être percée à jour.
Avec leurs collègues de Sheffield, de Glasgow et de l'Imperial College, les scientifiques de Newcastle apportent la première image précise de cet assemblage et de la structure de la principale protéine SlpA, qui forme cette armure selon un motif bien précis. L’objectif serait maintenant de concevoir des traitements capables de briser cette couche protectrice ou de bouleverser cet arrangement pour permettre au médicament d'entrer et de tuer la cellule.
L’armure, une couche de surface ou « couche S ».
Une armure en forme de cotte de mailles : l'un des nombreux moyens dont dispose la superbactérie Clostridioides difficile, pour se protéger des antibiotiques est cette enveloppe protectrice spéciale qui recouvre la cellule de la bactérie entière : la couche de surface ou couche S. Sa structure basée sur un agencement bien spécifique des protéines est ici décryptée à l'aide de techniques de rayons X et de cristallographie électronique.
Une cotte à base de protéine SlpA : l’un des auteurs principaux, le Dr Paula Salgado, maître de conférences en cristallographie macromoléculaire travaille sur cette structure depuis plus de 10 ans. Cette nouvelle étude a permis de préciser l’action de la protéine SlpA, qui s’agence avec des ouvertures très étroites qui empêchent la pénétration des antibiotiques et des agents du système immunitaire.
De futurs médicaments qui ciblent la cotte de mailles et créent des trous dans l’armure de la bactérie, pourraient constituer un nouvel axe de lutte contre les infections nosocomiales et contre la résistance aux antimicrobiens (RAM) considérée aujourd’hui par l'OMS comme l'une des 10 principales menaces mondiales pour la santé publique.
Différentes bactéries, différents mécanismes de résistance : les différentes stratégies bactériennes de résistance aux antibiotiques et les différences structurelles rendent difficile d’identifier une stratégie unique pour combattre ces super bactéries. Ici, dans le cas de C. difficile, c’est le décryptage précis de cette armure spécifique qui ouvre une nouvelle piste thérapeutique. Ainsi, l'utilisation de bactériophages qui se fixent et détruisent à la couche S. est déjà à l’étude.
Autres actualités sur le même thème
CICATRISATION des PLAIES : L'oxyde de zinc réduit les odeurs et l’inflammation
Actualité publiée il y a 6 années 11 moisANTIBIORÉSISTANCE : Les bactéries se passent le mot pour échapper au traitement
Actualité publiée il y a 6 années 4 moisULCÈRE du PIED DIABÉTIQUE: Pourquoi l'attitude du patient est déterminante
Actualité publiée il y a 9 années 11 moisTÉLÉMEDECINE et SOIN de PLAIES : Satisfaction des patients en post-op
Actualité publiée il y a 7 années 2 mois